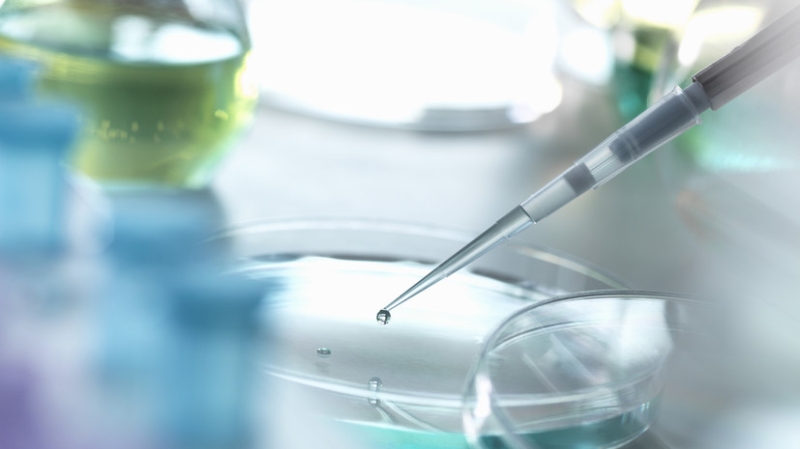
В Роспотребнадзоре исключили угрозу эпидемии сибирской язвы в России

В России исключена угроза эпидемического распространения сибирской язвы, заявили в Роспотребнадзоре.
«Роспотребнадзор подчёркивает, что угроза эпидемического распространения болезни исключена. Сибирская язва не передается от человека к человеку», — приводит ТАСС сообщение ведомства.
Ранее министр здравоохранения Михаил Мурашко заявил о локализации очагов сибирской язвы в России.
Эксперты Роспотребнадзора рассказали о симптомах инфицирования сибирской язвой и способах профилактики заболевания.












